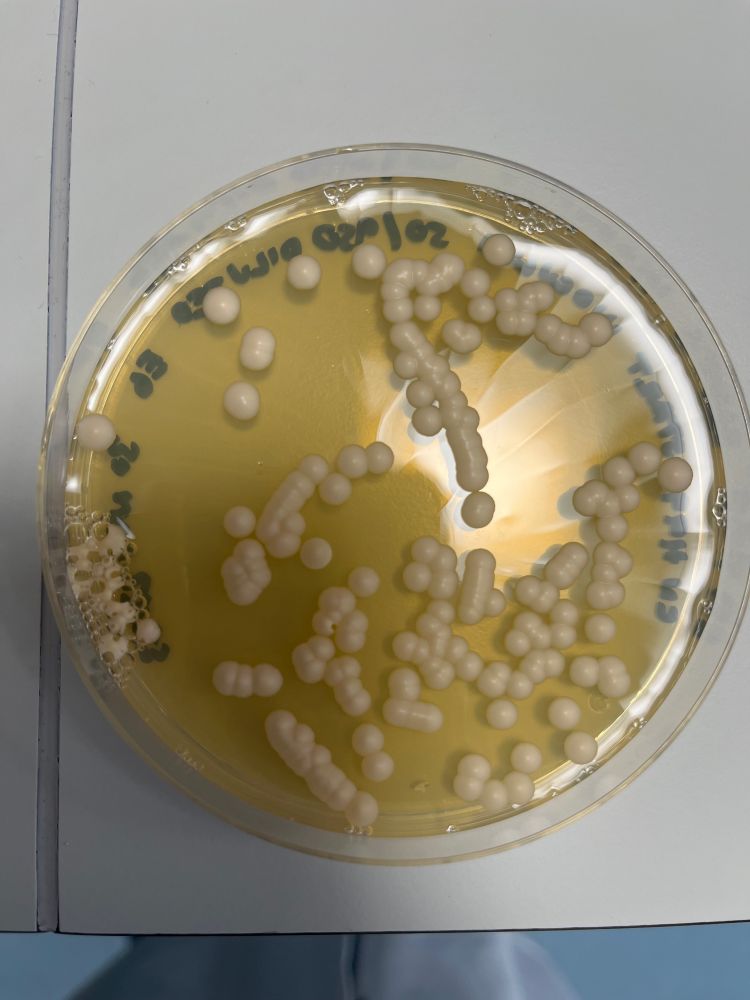

Prototype mRNA vaccines imprint broadly neutralizing human serum antibodies after Omicron variant-matched boosting
Immune imprinting is a phenomenon in which an individual's prior antigenic experiences influence responses to subsequent infection or vaccination. Here, using antibody depletion and multiplexed spike-binding assays, we characterized the type-specificity and cross-reactivity of serum antibody responses after mRNA vaccination in mice and human clinical trial participants. In mice, a single priming dose of a preclinical version of mRNA-1273 vaccine encoding Wuhan-1 spike minimally imprinted serum responses elicited by Omicron boosters, enabling a robust generation of type-specific antibodies. However, substantial imprinting was observed in mice receiving an Omicron booster after two priming doses of mRNA-1273, an effect that was mitigated by a second booster dose of Omicron mRNA vaccine. In humans who received two BA.5 or XBB.1.5 Omicron-matched boosters after two or more doses of the prototype mRNA-1273 vaccine, spike-binding and neutralizing serum antibodies cross-reacted with circulating Omicron variants as well as more distantly related sarbecoviruses. Because the serum neutralizing response against Omicron strains and other sarbecoviruses was completely abrogated after pre-clearing with the Wuhan-1 spike protein, antibodies induced by XBB.1.5 boosting in humans focus on conserved epitopes shaped and shared by the antecedent mRNA-1273 primary series. Our depletion analysis also identified cross-reactive neutralizing antibodies that recognize distinct epitopes in the receptor binding domain (RBD) and S2 proteins with differential inhibitory effects on members of the sarbecovirus subgenus. Thus, although the serum antibody response to Omicron-based boosters in humans is dominantly imprinted by prior immunizations with prototype mRNA-1273 vaccines, this outcome can be beneficial as it drives expansion of multiple classes of cross-neutralizing antibodies that inhibit infection of emerging SARS-CoV-2 variants and extend activity to distantly related sarbecoviruses.
### Competing Interest Statement
M.S.D. is a consultant or advisor for Inbios, Vir Biotechnology, IntegerBio, Moderna, Merck Sharp & Dohme Corporation, and GlaxoSmithKline. The Diamond laboratory has received additional unrelated funding support in sponsored research agreements from Vir Biotechnology, Emergent BioSolutions, and IntegerBio. G.A.A., S.M.E, and D.K.E. are employees of and shareholders in Moderna, Inc. J.E.C. has served as a consultant for Luna Labs USA, Merck Sharp & Dohme Corporation, Emergent Biosolutions, GlaxoSmithKline, and BTG International Inc, is a member of the Scientific Advisory Board of Meissa Vaccines, a former member of the Scientific Advisory Board of Gigagen (Grifols) and is founder of IDBiologics. The laboratory of J.E.C. received unrelated sponsored research agreements from AstraZeneca, Takeda Vaccines, and IDBiologics during the conduct of the study. Vanderbilt University has applied for a patent concerning antibodies that are related to this work (U.S. Provisional Patent Application No. 63/513,255). All other authors declare no competing interests.